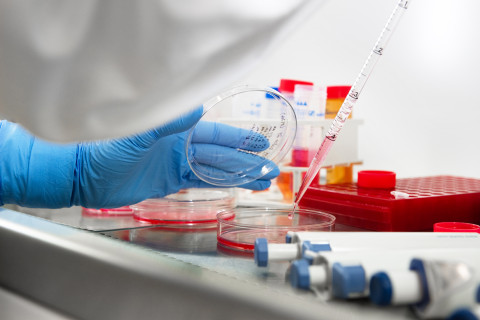

Uudella ihmisen kantasolumallilla tehty tutkimus paljastaa, että Alzheimerin taudin yleisin riskitekijä, apolipoproteiini E4, vaikuttaa erityisesti ihmisen aivojen tulehdussolujen, mikrogliojen, toimintoihin. Tulokset voivat avata uusia hoitomahdollisuuksia Alzheimerin tautiin. Tutkimus julkaistiin arvostetussa Stem Cell Reports -tiedelehdessä.
Voidakseen tutkia ihmisen aivosoluja hallitusti laboratoriossa tutkijat kehittivät ensin menetelmän, jolla potilaan omista ihosoluista tuotetuista kantasoluista voidaan tuottaa rajaton määrä potilaan perimää kantavia mikroglioja. Tutkimus toteutettiin Itä-Suomen yliopistossa yhteistyössä Australian Wollongongin yliopiston ja Helsingin yliopiston kanssa.
Alzheimerin taudin perimmäistä syytä ei tunneta. Tiedetään kuitenkin, että ikääntymisen myötä ja sairauden edetessä aivoihin kertyy haitallista proteiinia, amyloidia, joka vaurioittaa hermoratoja ja aivosoluja. Tautia hidastavaa hoitoa ei ole keksitty ja useat eläinkokeissa lupaavilta vaikuttaneet lääkeaineet ovat osoittautuneet ihmisillä tehdyissä hoitokokeissa tehottomiksi. Tutkimuksissa on keskitytty etsimään keinoja pääasiassa amyloidituotannon vähentämiseen.
Mikrogliasolut poistavat amyloidia fagosytoosiksi kutsutulla mekanismilla. Ne huolehtivat myös aivojen tulehdusvasteesta, jossa erityisesti on havaittu eroja ihmisen ja eläinmallien välillä. Alzheimerin taudissa mikrogliojen toiminta on häiriintynyt, mutta ei tiedetä, miksi mikrogliat eivät kykene poistamaan myrkyllistä amyloidia potilaiden aivoista. Sen sijaan ne joko menettävät toimintakykynsä tai aktivoituvat haitallisesti lisäten hermosolujen kuolemaa.
APOE4-genotyyppi on tärkein perinnöllinen Alzheimerin taudin riskitekijä, jonka tiedetään varhentavan taudin alkamisikää. Apolipoproteiini E eli APOE osallistuu kehossa rasvojen kuten kolesterolin kuljetukseen ja sillä on merkittävä rooli myös aivojen hermosolujen vaurioiden korjauksessa. Se esiintyy ihmisissä kolmessa eri muodossa: E2, E3 ja E4. Perimä määrää, mitä muotoja henkilö kantaa. Vain APOE4-muoto altistaa Alzheimerin taudille, ja yli puolet Alzheimerin tautia sairastavista henkilöistä kantaa tätä muotoa. APOE-geeniä ilmennetään runsaasti ihmisen mikroglioissa, mutta sen tarkkaa tehtävää soluissa ei tunneta hyvin.
Nyt julkaistussa tutkimuksessa osoitettiin, että APOE4 voimistaa ihmisen mikrogliojen tulehdusvastetta, mutta toisaalta heikentää solujen kykyä liikkua ja poistaa haitallista materiaalia. Nämä toiminnot ovat tärkeitä aivojen tasapainotilan ylläpitämisessä, sairauksilta suojautumisessa sekä ikääntymisen myötä tapahtuvan solukuoleman hallinnassa. Lisäksi tutkimuksessa havaittiin ensimmäistä kertaa, että APOE4 heikentää ihmisen mikrogliojen aineenvaihduntaa. Nämä havainnot osoittavat, että APOE4 vaikuttaa ihmisen mikrogliojen toimintaan perustavanlaatuisesti. Mikrogliojen aineenvaihdunnasta voikin tulla vaihtoehtoinen kohde uusille Alzheimerin tautiin kehitettäville hoidoille.
Tämä tutkimus tuo esiin uuden, hoidon kannalta kiinnostavan havainnon: mikroglioilla voi olla merkittäviä vaikutuksia Alzheimerin taudin kulkuun riippumatta niiden kyvystä puhdistaa aivojen amyloidikertymiä. Potilaan omista soluista tuotettavat kantasolut ja niistä erilaistettavat mikrogliat mahdollistavat myös muiden aivosairauksien mekanismien ja uusien lääkeaineiden tutkimisen aivosoluissa ihmisen geneettistä taustaa vasten.
Lisätietoja:
Nuorempi tutkija Henna Konttinen, Itä-Suomen yliopisto, A.I. Virtanen -instituutti, henna.konttinen (a) uef.fi
Professori Tarja Malm, Itä-Suomen yliopisto, A.I. Virtanen -instituutti, p. +358 40 3552209, tarja.malm (a) uef.fi
Tutkimusartikkeli:
PSEN1ΔE9, APPswe and APOE4 confer disparate phenotypes in human iPSC-derived microglia. Stem Cell Reports (2019). Henna Konttinen, Mauricio e Castro Cabral-da-Silva, Sohvi Ohtonen, Sara Wojciechowski, Anastasia Shakirzyanova, Simone Caligola, Rosalba Giugno, Yevheniia Ishchenko, Damián Hernández, Mohammad Feroze Fazaludeen, Shaila Eamen, Mireia Gómez Budia, Ilkka Fagerlund, Flavia Scoyni, Paula Korhonen, Nadine Huber, Annakaisa Haapasalo, Alex W. Hewitt, James Vickers, Grady C. Smith, Minna Oksanen, Caroline Graff, Katja M. Kanninen, Sarka Lehtonen, Nicholas Propson, Michael P. Schwartz, Alice Pébay, Jari Koistinaho, Lezanne Ooi, Tarja Malm. Julkaistu verkossa 12.9.2019. https://www.cell.com/stem-cell-reports/fulltext/S2213-6711(19)30298-X